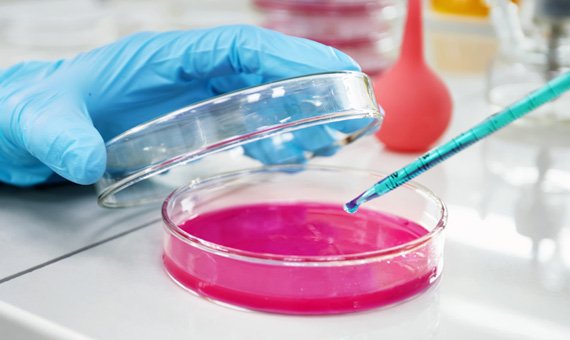

-
322 US 46 SUITE 160W PARSIPPANY, NEW JERSEY 07054
-
Mon - Fri: 09.00AM - 06.00PM

Years of
Your Trusted Partner in Accurate Diagnostics
At Lumina Diagnostic Laboratory, we believe good health starts with the right diagnosis. Based in New Jersey, we provide a full range of reliable, affordable, and advanced laboratory testing services designed to help patients and healthcare providers make confident decisions.
Who We Are
We’re more than just a lab — we’re your healthcare partners. Our experienced team of professionals combines compassion with cutting-edge technology to deliver quick, accurate, and precise test results.
Our Mission
To make quality healthcare accessible to everyone through trusted testing, exceptional service, and continuous innovation.
This is how we can help you
Allergy Testing
Identify allergic reactions quickly with precise testing. We help you understand triggers and manage symptoms effectively.
Cardiovascular Disease
Comprehensive heart screenings to detect risks early. Stay proactive in maintaining a healthy heart and lifestyle.
Coagulation
Accurate blood clotting tests to monitor bleeding or clotting disorders. Essential for safe treatments and medication management.


Antibody Test
2025Leaders in diagnostic services
At Lumina Diagnostic Laboratory, we’re more than just a testing facility — we’re your partners in better health. Our goal is to make every diagnostic experience easy, accurate, and stress-free. With a perfect blend of modern technology and compassionate care, we deliver results you can depend on.
- Accurate Results
- Fast Turnaround
- Certified Professionals
- Patient-Centered Care